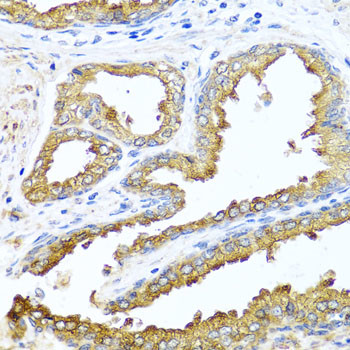
NCK2 Antibody in Immunohistochemistry (Paraffin) (IHC (P))

Search
Invitrogen
NCK2 Polyclonal Antibody
{{$productOrderCtrl.translations['antibody.pdp.commerceCard.promotion.promotions']}}
{{$productOrderCtrl.translations['antibody.pdp.commerceCard.promotion.viewpromo']}}
{{$productOrderCtrl.translations['antibody.pdp.commerceCard.promotion.promocode']}}: {{promo.promoCode}} {{promo.promoTitle}} {{promo.promoDescription}}. {{$productOrderCtrl.translations['antibody.pdp.commerceCard.promotion.learnmore']}}
图: 1 / 2
NCK2 Antibody (PA5-96788) in IHC (P)


Please note: We are reviewing Western blot images included in the antibody testing data in our catalog, including those provided by third parties. Unless expressly labeled or annotated as “raw-unedited”, Western blot images included in the antibody testing data in our catalog may have been edited, optimized or otherwise adjusted for presentation.
产品信息
PA5-96788
种属反应
宿主/亚型
分类
类型
抗原
偶联物
形式
浓度
规格
纯化类型
保存液
内含物
保存条件
运输条件
RRID
产品详细信息
Immunogen sequence: MTEEVIVIAK WDYTAQQDQE LDIKKNERLW LLDDSKTWWR VRNAANRTGY VPSNYVERKN SLKKGSLVKN LKDTLGLGKT RRKTSARDAS PTPSTDAEYP ANGSGADRIY DLNIPAFVKF AYVAEREDEL SLVKGSRVTV MEKCSDGWWR GSYNGQIGWF PSNYVLEEVD EAAAESPSFL SLRKGASLSN GQGSRVLHVV QTLYPFSSVT EEELNFEKGE TMEVIEKPEN DPEWWKCKNA RGQVGLVPKN YVVVLSDGPA LHPAHAPQIS YTGPSSSGRF AGREWYYGNV TRHQAECALN ERGVEGDFLI RDSESSPSDF SVSLKASGKN KHFKVQLVDN VYCIGQRRFH TMDELVEHYK KAPIFTSEHG EKLYLVRALQ; Positive Samples: 293T, Mouse lung, Rat brain; Cellular Location: Cytoplasm, Endoplasmic reticulum
靶标信息
The NCK family of SH2/SH3 adaptor proteins consists of two members, NCK1 and NCK2, which couple tyrosine kinase signaling, including the EGF and PDGF receptor-pathways, to downstream signaling proteins. The NCK2 protein binds human PDGFR-b (Tyr-1009); overexpression of NCK2 inhibits PDGF-induced membrane ruffling and lamellipod formation.
仅用于科研。不用于诊断过程。未经明确授权不得转售。
篇参考文献 (0)
生物信息学
蛋白别名: Cytoplasmic protein NCK2; Growth factor receptor-bound protein 4; NCK adaptor protein 2; Nck-2; non-catalytic region of tyrosine kinase adaptor protein 2; SH2/SH3 adaptor protein NCK-beta
基因别名: 4833426I10Rik; Grb4; Nck-2; Nck2; NCKbeta
UniProt ID: (Mouse) O55033
Entrez Gene ID: (Mouse) 17974, (Rat) 316369